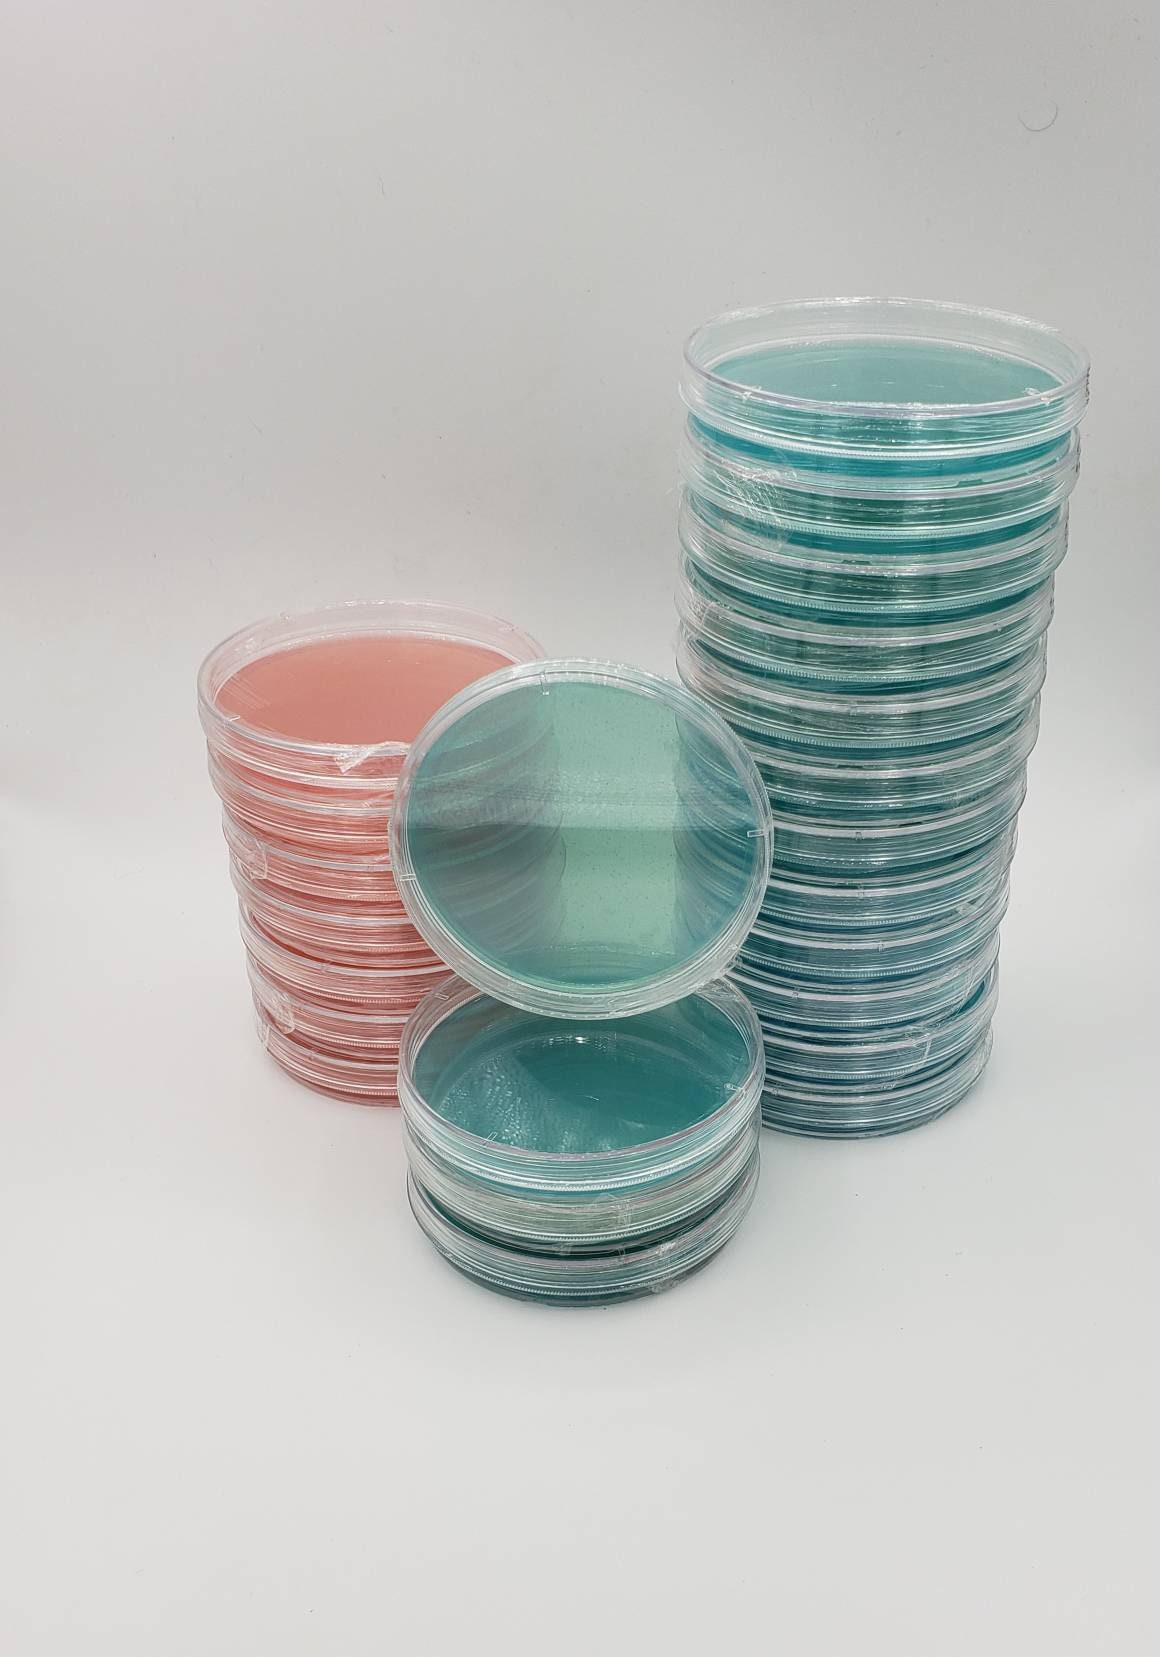

Add a title to introduce your product's features
Highlights
Provide details in each of the collapsible rows to give your customers the information they need to pick the best product.
Change the title and icon of each row to suit your brand.
Scent
Details
Ingredients
Feature a compelling customer review about your product or brand.
- CUSTOMER NAME HERE -
-
Multicolumn
Use a combination of images and text to share information about this product, and your brand.
-
Multicolumn
Consider adding information about your shipping and return policies.
-
Multicolumn
Consider highlighting your environmental commitments.
-
Multicolumn
Consider describing a money-back guarantee or highlighting your customer service.
Introduce other complementary products.
DESCRIBE HOW TO PAIR PRODUCTS TOGETHER
Image with text
Pair text with an image to focus on your chosen product. Add details on availability, style, or even provide a review.
Image with text
Pair text with an image to focus on your chosen product. Add details on availability, style, or even provide a review.
Image with text
Pair text with an image to focus on your chosen product. Add details on availability, style, or even provide a review.